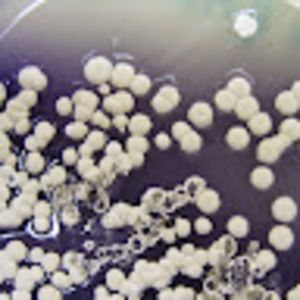
Meet your Posher, Brad

BradH
@bahaltli
Sort By:
C$0
Size: OS
Meet the Posher
bahaltli
In United States. Switch to Canada to see listings in this closet
Open Closet in Canada